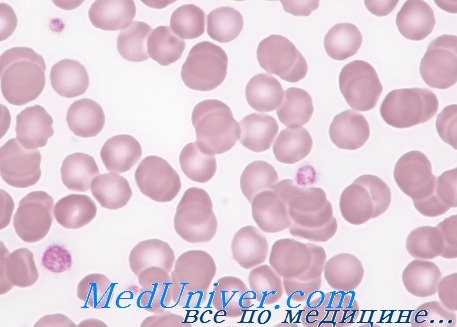
тромбоцитопении у детей

Врожденные внутренние нарушения тромбоцитов
Добавил пользователь Cypher Обновлено: 18.12.2025
Тромбоцитопении у детей: причины, диагностика, лечение
Тромбоцитопения — состояние, при котором количество тромбоцитов ниже 150х109/л. Риск кровотечений зависит от количества тромбоцитов.
• Тяжёлая тромбоцитопения (количество тромбоцитов • Умеренная тромбоцитопения (количество тромбоцитов 20-50х109/л) — риск избыточного кровотечения во время операций или при травме, но невысокий риск спонтанных кровотечений.
• Лёгкая тромбоцитопения (количество тромбоцитов 50-150х109/л) — низкий риск кровотечения во время операций или при травме. Тромбоцитопения может приводить к формированию кровоподтёков, петехиям, пурпуре и кровотечениям из слизистых (например, носовым, из дёсен при чистке зубов). Обширное кровотечение в форме тяжёлого желудочно-кишечного кровотечения, гематурии и внутричерепного кровоизлияния встречается намного реже.
Хотя пурпура может обозначать тромбоцитопению, она также происходит при нормальном количестве тромбоцитов вследствие дисфункции тромбоцитов и сосудистых нарушений.
Иммунная тромбоцитопения
Иммунная тромбоцитопения (также называемая тромбоцитопенической пурпурой) — наиболее распространённая причина тромбоцитопении в детском возрасте. Распространенность её составляет около 4 на 100 000 детей в год.
Она возникает в результате иммуноопосредованной деструкции циркулирующих тромбоцитов под действием антитромбоцитарных антител. Снижение количества тромбоцитов сопровождается компенсаторным увеличением мегакариоцитов в костном мозге.
Клинические признаки иммунной тромбоцитопении у детей
У большинства детей клинические признаки появляются в возрасте между 2 и 10 годами, часто с началом заболевания спустя 1-2 нед после перенесённой вирусной инфекции. Анамнез обычно короткий, занимает дни или недели. У поражённых детей развиваются петехии, пурпура и поверхностные кровоподтёки. Также могут развиться носовое и другие кровотечения из слизистых, однако профузные кровотечения нетипичны, несмотря на тот факт, что количество тромбоцитов обычно снижается до 10х109/л.
Внутричерепные кровоизлияния — серьёзные, но редкие осложнения, происходят в 0,1-0,5% случаев в основном у тех, у кого тяжёлая тромбоцитопения присутствует в течение длительного периода.
Диагностика иммунной тромбоцитопении у детей
Иммунная тромбоцитопения — диагноз исключения, поэтому необходимо уделить большое внимание анамнезу, клиническим особенностям и мазку крови для того, чтобы быть уверенным, что ни один более тяжёлый диагноз не был пропущен. У детей младшего возраста необходимо предположить врождённые причины (такие как синдромы Вискотта-Олдрича или Бер-нара-Сулье). Любые атипичные клинические проявления, как, например, наличие гепатоспленоме-галии или выраженной лимфаденопатии, требуют немедленного исследования костного мозга для исключения острой лейкемии или апластической анемии.
Необходимо провести исследование костного мозга, если планируется лечение ребёнка глюкокортикоидами, поскольку эта терапия может временно маскировать эти заболевания. Также необходимо предположить СКВ. Однако если имеются характерные клинические симптомы при отсутствии изменений в крови, за исключением низкого количества тромбоцитов, и нет намерения проводить лечение, то исследование костного мозга не требуется.
При иммунной тромбоцитопении, за исключением выразительных кожых проявлений и значительно сниженного количества тромбоцитов, состояние хорошее и у большинства пациентов происходит быстрая ремиссия без каких-либо вмешательств.
Ведение детей с иммунной тромбоцитопенией
Приблизительно у 80% детей болезнь протекает остро, доброкачественно и обычно спонтанно разрешается в течение 6-8 нед. Большинству детей помощь может оказываться на дому, госпитализация и не требуется. Подход к лечению противоречивый. Большинству детей не требуется никакая терапия, даже если количество тромбоцитов составляет менее 10х109/л, однако необходимо начать лечение, если есть признаки массивного кровотечения (например, внутричерепного или желудочно-кишечного) или продолжающееся небольшое кровотечение (например, постоянная кровоточивость ротовой полости).
Для лечения используется преднизолон внутрь или иммуноглобулин внутривенно, однако оба они имеют значительные побочные эффекты и не влияют на шанс достижения полной ремиссии. Инфузии иммуноглобулина обычно приводят к более быстрому увеличению числа тромбоцитов, чем глюкокортикоиды. Трансфузии тромбоцитарной массы оставляют для жизнеугрожающих кровотечений, поскольку они поднимают уровень тромбоцитов лишь на несколько часов. Преднизолон должен применяться лишь короткими курсами независимо от числа тромбоцитов. У родителей должен быть свободный 24-часовой доступ в клинику.
Ребёнок должен избегать травм, насколько это возможно, и контактных видов спорта до тех пор, пока сохраняется очень низкое число тромбоцитов.
Хроническая иммунная тромбоцитопения у детей
У 20% детей количество тромбоцитов остаётся низким через 6 мес после установления диагноза, это известно как хроническая иммунная тромбоцитопения у детей. Никакое лечение не проводится до тех пор, пока не произойдет массивное кровотечение. Как и при острой иммунной тромбоцитопении у детей, не должны применяться длительные курсы глюкокортикоидной терапии. Поэтому терапия в основном поддерживающая, ребёнок должен избегать контактных видов спорта, однако должен стимулироваться для продолжения нормальной жизнедеятельности, в том числе посещения школы.
Как и при острой иммунной тромбоцитопении у детей, родителям необходим 24-часовой доступ к медицинской помощи. Семье может пойти на пользу общение с группой поддержки родителей детей, страдающих иммунной тромбоцитопенией. У большинства детей наступает выздоровление в течение 3 лет или стабилизация с сохранением умеренной асимптомной тромбоцитопении. Случаи профузных кровотечений являются редкими и требуют помощи специалистов. Спленэктомия является, вероятно, наиболее эффективным лечением в этой группе пациентов, но приводит к значительному увеличению заболеваемости и в 25% случаев может оказаться бесполезным. Если иммунная тромбоцитопения у ребёнка переходит в хроническую форму, требуется проведение регулярных обследований на наличие СКВ, поскольку тромбоцитопения может предшествовать появлению маркёров этого заболевания.
Редактор: Искандер Милевски. Дата обновления публикации: 18.3.2021
Тромбоцитопатии
Тромбоцитопатии - группа наследственных и приобретенных нарушений гемостаза, возникающих вследствие качественной неполноценности тромбоцитов при их нормальном количестве. Тромбоцитопатии у детей проявляются склонностью к образованию петехий и гематом при незначительных травмах, кровотечениям (носовым, желудочно-кишечным, маточным) различной степени выраженности, анемией. Выявление тромбоцитопатии у детей требует тщательного лабораторного исследования системы гемостаза, проведения функциональных проб, пункции и исследования костного мозга и др. Лечение тромбоцитопатии у детей проводится детским гематологом и включает общую и местную гемостатическую терапию.

Общие сведения
Тромбоцитопатии – геморрагические диатезы, развивающиеся в результате нарушения первичного тромбоцитарного звена гемостаза. Популяционная частота тромбоцитопатий достигает 5-10%. Наследственные тромбоцитопатии являются наиболее частой причиной кровотечений неясного генеза у детей; на их долю приходится от 36 до 65%. Тромбоцитопатии представляют собой актуальную проблему для педиатрии и детской гематологии, поскольку их распространенность зачастую недооценивается, и многие дети с геморрагическим синдромом длительно и безуспешно лечатся у специалистов узкого профиля – детских отоларингологов, детских гинекологов, детских стоматологов, детских гастроэнтерологов, детских урологов.

Классификация тромбоцитопатий
Тромбоцитопатии объединяют в себе гетерогенную группу заболеваний, которые могут быть поделены на наследственные (врожденные) и приобретенные (симптоматические).
1. Наследственные тромбоцитопатии:
- с нарушением агрегационной функции тромбоцитов - дизагрегационные тромбоцитопатии (эссенциальная атромбия 1 типа, тромбастения Гланцмана, аномалия Пирсона-Стоба, аномалия Мея-Хегглина и др.)
- с дефектом реакции освобождения (эссенциальная атромбия 2 типа, аспириноподобный синдром и др.)
- с недостаточным хранением гранул и их компонентов (синдром «серых тромбоцитов», синдром Хержманского-Пудлака)
- с нарушением адгезии тромбоцитов (болезнь Виллебранда, макроцитарная тромбоцитодистрофия Бернара-Сулье)
- тромбоцитопатии, сочетающиеся с различными врожденными дефектами (врожденными пороками сердца, гликогенозами, синдромом Марфана, Элерса-Данлоса, Вискотта-Олдрича и др.)
2. Приобретенные тромбоцитопатии, развивающиеся в течение жизни на фоне других заболеваний.
В детском возрасте наследственные тромбоцитопатии встречаются в 3 раза чаще, чем приобретенные.
Причины тромбоцитопатий
Первичный тромбоцитарно-сосудистый гемостаз включает в себя ряд последовательных реакций: адгезии, агрегации, ретракции кровяного сгустка и активации плазменного гемостаза.
При повреждении кровеносного сосуда под воздействием главного стимулятора адгезии – коллагена эндотелия, тромбоциты набухают и приклеиваются к стенке сосуда. В реализации этапа первичного гемостаза участвуют ионы Ca, белок эндотелия - фактор Виллебранда и контактирующий с ним мембранный гликопротеин Ib тромбоцитов. Вслед за адгезией начинается фаза агрегации, в процессе которой происходит быстрое увеличение тромба. В эту фазу выделяются биологически активные вещества (тромбин, аденозинфосфат (АДФ), катехоламины, серотонин и мн. др.), вызывающие вазоконстрикцию и усиливающие адгезию и агрегацию тромбоцитов. Под влиянием происходящих процессов рыхлая тромбоцитарная пробка уплотняется и подвергается ретракции – сокращению с самопроизвольным отделением сыворотки от сгустка.
Причиной наследственных тромбоцитопатий выступают дефекты генов, кодирующих те или иные факторы, принимающие участие в обеспечении тромбоцитарно-сосудистого гемостаза. Врожденные тромбоцитопатии могут наследоваться по аутосомно-доминантному или аутосомно-рецессивному типу.
Функциональная неполноценность тромбоцитов при приобретенных тромбоцитопатиях может быть связана с приемом тромбоцитоактивных лекарственных препаратов (НПВС, аспирина, пенициллинов, антикоагулянтов и др.), В12-дефицитной анемией, ДВС-синдромом, лейкозом, циррозом печени, геморрагическим васкулитом, системной красной волчанкой, диффузным гломерулонефритом, почечной недостаточностью, гигантскими ангиомами, тромбозами, массивными гемотрансфузиями, лучевой болезнью и пр.
Симптомы тромбоцитопатий
Диапазон проявлений тромбоцитопатии у детей очень широк. Клиническая манифестация врожденной тромбоцитопатии может быть связана с перинатальной патологией (ацидозом, гипоксией), родовыми травмами, вирусными или бактериальными инфекциями, сепсисом, гиповитаминозом, инсоляцией, проведением физиотерапевтических процедур (УФО, УВЧ), массажа, прививки и др.
Ведущим в клинике различных форм тромбоцитопатии является рецидивирующий геморрагический синдром, тяжесть которого может варьировать от легкой кровоточивости до обильных кровотечений. У новорожденных тромбоцитопатия может проявляться кефалогематомами, внутричерепными кровоизлияниями, кровоточивостью и медленным заживлением пупочной ранки. Кровотечения микроциркулярного типа характеризуются петехиями, экхимозами, возникающими при незначительных травмах, трении тела одеждой. В отличие от гемофилии, для тромбоцитопатии не характерны гемартрозы и межмышечные гематомы.
При тромбоцтопатиях у детей раннего возраста отмечаются кровотечения при прорезывании зубов, рецидивирующие носовые кровотечения, повышенная кровоточивость десен, длительное заживление мелких повреждений. У девочек-подростков часто имеется «семейная» склонность к меноррагиям, ювенильным дисфункциональным маточным кровотечениям. У пациентов с тромбоцитопатиями даже малые хирургические вмешательства (удаление зуба, тонзиллэктомия и др.) сопровождаются обильными и длительными кровотечениями. Реже в клинике тромбоцитопатий встречаются желудочно-кишечные кровотечения, гематурия, кровоизлияния в склеры.
Вследствие повышенной кровопотери у детей с тромбоцитопатиями развивается анемический синдром, характеризующийся общей слабостью, бледностью кожных покровов, головокружениями, одышкой, тахикардией, артериальной гипотонией, склонностью к обморокам.
При сочетании тромбоцитопатии с дисплазией соединительной ткани у детей выявляются нарушения осанки, плоскостопие, нефроптоз, пролапс митрального клапана и др. аномалии развития.
Диагностика тромбоцитопатий
Как показывает практика, диагноз тромбоцитопатии у детей редко устанавливается своевременно. Участковые педиатры, как правило, не придают должного значения геморрагическим проявлениям и направляют детей к узким специалистам: детскому ЛОРу – при носовых кровотечениях; детскому гинекологу – при обильных менструациях; детскому стоматологу – при кровоточивости десен и т. д. Между тем, дети с тромбоцитопатиями нуждаются в как можно более ранней специализированной консультации гематолога для уточнения диагноза и формы тробоцитопатии.
Диагностика тромбоцитопатии включает несколько этапов, главными из которых являются анализ клинических проявлений и семейного анамнеза, углубленное исследование системы гемостаза. Функциональные эндотелиальные пробы (баночная, манжеточная, щипковая, проба жгута) при тромбоцитопатиях, как правило, положительные: на коже, в месте воздействия остаются многочисленные петехии или кровоподтек.
Лабораторный этап диагностики тромбоцитопатии начинается с клинического анализа крови, определения времени кровотечения, показателей коагулограммы. В процессе диагностического поиска тромбоцитопатии проводится определение количества тромбоцитов и тромбоцитарной формулы, изучение их морфометрических характеристик и функции (адгезивности; агрегационной активности тромбоцитов с АДФ, ристомицином, адреналином, тромбином, коллагеном; определение тромбоцитарных факторов свертывания и др.). Лабораторное обследование ребенка с тромбоцитопатией должно выполняться не менее 3-х раз в разные периоды заболевания (во время клинической ремиссии и в момент геморрагических проявлений).
Для оценки функции кроветворения в некоторых случаях назначается проведение стернальной пункции или трепанобиопсии и исследование миелограммы.
Лечение тромбоцитопатий
При наследственных тромбоцитопатиях проведение этиотропного лечения невозможно. Поэтому весь комплекс терапевтических мероприятий делится на неотложную терапию по купированию геморрагического синдрома и профилактическое лечение. В течение всей жизни пациентам с тромбоцитопатией запрещается употребление уксуса с пищей (в т. ч. в консервах), алкоголя. Рекомендуется обогащение рациона продуктами, богатыми витаминами А, С и Р; арахисом.
Медикаментозная терапия тромбоцитопатии проводится гемостатическими средствами (этамзилат натрия, адроксон, кальция глюконат, аминокапроновая кислота и др.), препаратами метаболического действия (инозин, АТФ, оротат калия, фолиевая кислота). Полезно употребление кровоостанавливающих фитосборов. Плановые профилактические курсы лечения тромбоцитопатии рекомендуется проводить 2-4 раза в год в зависимости от тяжести геморрагического синдрома.
Для локальной остановки кровотечений из поверхностных ран используется орошение кровоточащей поверхности охлажденным раствором аминокапроновой кислоты, нанесение адроксона, аппликации фибринной пленки с тромбином. При носовом кровотечении необходимо ведение в носовые ходы гемостатической губки, проведение анемизации слизистой носа. При маточных кровотечениях применяются препараты, усиливающие сокращение матки (этистерон), внутривенное введение аминокапроновой кислоты; РДВ полости матки при тромбоцитопатии должно проводится под прикрытием гемостатической терапии. При массивной кровопотере может потребоваться переливание эритроцитарной массы, тромбоцитов и плазмы.
При симптоматической тромбоцитопатии необходимо проведение лечения основного заболевания, исключение приема тромбоцитоактивных препаратов и других провоцирующих моментов.
Прогноз и профилактика тромбоцитопатии
Своевременное выявление тромбоцитопатии у ребенка и проведение адекватной профилактической терапии позволяет предупредить выраженную кровопотерю и повысить качество жизни. При массивных внутричерепных геморрагиях, сопровождающих течение некоторых форм тромоцитопатии, прогноз для жизни неблагоприятный.
Мерами профилактики тромбоцитопатий служат медико-генетическое консультирование семей с наследуемым геморрагическим синдромом, отказ от бесконтрольного приема медикаментов. Дети с установленным диагнозом тромбоцитопатии должны находиться на диспансерном учете у педиатра, детского гематолога, детского офтальмолога, ЛОРа, стоматолога; регулярно проходить полное лабораторное обследование, получать превентивное лечение, исключить занятия травмоопасными видами спорта. Вопрос о проведении профилактической вакцинации детей решается в индивидуальном порядке.
Тромбоцитоз
Тромбоцитоз – это патологическое состояние, характеризующееся увеличением содержания в крови тромбоцитов. Причиной данного явления выступают инфекционные, воспалительные или аутоиммунные патологии, а также злокачественные опухоли кроветворной системы. У детей часто возникает на фоне железодефицитной анемии. Клиническая картина может быть различной и определяется основным заболеванием. Уровень кровяных пластинок, как часть общего анализа крови, исследуется в венозной или капиллярной крови. Для коррекции тромбоцитоза проводится лечение болезни, на фоне которой он развился.
Классификация
Верхняя граница нормального значения тромбоцитов варьирует от 350 000 до 400 000 в 1 мкл в зависимости от референсных интервалов конкретной лаборатории, выполняющей анализ. По степени увеличения различают следующие виды тромбоцитоза:
- Мягкий: от 350-400 до 700 тыс.
- Умеренный: от 700 до 900 тыс.
- Тяжелый: от 900 до 1000 тыс.
- Экстремальный: более 1000 000.
Причиной экстремального и тяжелого тромбоцитоза выступают онкогематологические патологии. По происхождению тромбоцитозы бывают:
- Первичные (опухолевые, клональные). Составляют примерно 10-15% всех случаев тромбоцитоза. Причиной служат опухолевые болезни системы крови.
- Вторичные (реактивные). Наиболее частая разновидность (около 85%). Причиной выступают инфекционные, системные воспалительные процессы, анемии.
- Ложные (псевдотромбоцитозы). Причина ‒ ошибка гематологического анализатора, который принимает за тромбоциты фрагменты опухолевых клеток во время лечения химиотерапевтическими препаратами, эритроциты малых размеров или эритроциты, подвергшиеся гемолизу. Также псевдотромбоцитоз наблюдается при криоглобулинемии.
- Наследственный (семейный). Это редкое генетическое заболевание, причина которого лежит в мутации генов, кодирующих синтез тромбопоэтина и рецепторов к нему (THPO, MPL).
Причины тромбоцитоза
Физиологические состояния
Повышенный уровень тромбоцитов не всегда свидетельствует о патологии. Существует физиологический (кратковременный, транзиторный) тромбоцитоз, обусловленный различными обстоятельствами, например, стрессом, интенсивной физической нагрузкой. Причиной является мобилизация кровяных пластинок, а точнее их переход от краевого стояния к центральному кровотоку в сосудах селезенки, легких.
Кроме того, незначительный физиологический тромбоцитоз наблюдается у детей, начиная с периода новорожденности до 11 лет. Также существует так называемый гемоконцентрационный тромбоцитоз, причиной которого является обезвоживание. Данное явление обусловлено уменьшением объема жидкой части крови (плазмы) и относительным повышением форменных элементов (тромбоцитов, эритроцитов, лейкоцитов). В этой ситуации необходимо ориентироваться на гематокрит – при обезвоживании он повышен.
Инфекции
Это наиболее частая причина тромбоцитоза (около 40%). Повышение уровня кровяных пластинок развивается при:
- Бактериальных инфекциях. У взрослых тромбоцитоз возникает в основном при локальных (пневмония, пиелонефрит, менингит, эндокардит) и системных (сепсис, туберкулез) бактериальных инфекциях.
- Вирусных и грибковых инфекциях. Реже тромбоцитоз встречается при инфицировании вирусами (гепатит B, C) и патогенными грибками (аспергиллез).
- Гельминтозах. У детей распространенной причиной повышения числа кровяных пластинок признаны паразитарные инвазии (токсокароз, аскаридоз).
Существует два патогенетических механизма развития тромбоцитоза в ответ на инфекционное заболевание. Во-первых, во время борьбы с патогенами, лейкоциты продуцируют большое количество медиаторов воспаления, в том числе интерлейкина-6, который стимулирует костномозговой мегакарицитопоэз (образование предшественников тромбоцитов). Во-вторых, тромбоциты сами являются частью противоинфекционного иммунитета – они способны вырабатывать бактерицидные вещества, захватывать, нейтрализовывать, даже фагоцитировать некоторые виды бактерий, вирусов, чужеродных частиц.
Тромбоциты облегчают миграцию лейкоцитов к очагу инфекционного воспаления путем взаимодействия с эндотелиальными клетками сосудистой стенки. Тромбоцитоз при инфекциях возникает резко, коррелирует с тяжестью болезни, быстро разрешается после элиминации патогена из организма и стихания воспалительного процесса. Тромбоцитоз обычно мягкий или умеренный, при септическом состоянии может доходить до тяжелой степени, у детей несколько выраженнее, чем у взрослых.
Аутоиммунные заболевания
Другой частой причиной тромбоцитоза считаются хронические ревматологические патологии, протекающие с аутоиммунным воспалением. Механизм увеличения содержания кровяных пластинок заключается в гиперпродукции таких веществ, как интерлейкин-6, колониестимулирующие факторы, которые активизируют костномозговое тромбоцитообразование. Степень тромбоцитоза соответствует активности воспаления (минимальный в стадию ремиссии, максимальный во время рецидива).
При таких болезнях как ревматоидный артрит, системная красная волчанка (СКВ), воспалительные заболевания кишечника (болезнь Крона, неспецифический язвенный колит) наблюдается мягкая либо умеренная степень. При системных васкулитах с некротизирующей деструкцией стенок сосудов встречается тяжелый тромбоцитоз, так как при васкулитах, помимо прочих воспалительных медиаторов, в большом количестве синтезируется фактор некроза опухолей, также оказывающий стимулирующий эффект на тромбоцитообразование. Особенно часто высокие цифры тромбоцитов наблюдаются у детей.

Анемии
Нередко причиной тромбоцитоза, особенно у детей, выступает железодефицитная анемия. Точные механизмы этого явления до сих пор не выяснены, однако точно установлена обратная взаимосвязь между сниженными показателями метаболизма железа (ферритина, железосвязывающей способности сыворотки) и завышенным уровнем кровяных пластинок. Предполагается, что железо обладает подавляющим эффектом на созревание мегакариоцитов (клеток-предшественников).
Кроме того, часть плюрипотентных стволовых клеток костного мозга в условиях дефицита железа не способна превращаться в эритроциты. В результате происходит своеобразное «шунтирование» и больший процент стволовых клеток начинает созревать по мегакариоцитарному пути. Тромбоцитоз при железодефицитной анемии мягкий, иногда умеренный. Тромбоциты быстро приходят в норму после коррекции дефицита железа, увеличения гемоглобина.
Однако при усугублении анемии уровень тромбоцитов падает до состояния тромбоцитопении. Причиной железодефицита могут быть недостаток железа в пище, повышенный расход железа (период роста у детей, беременность, лактация) либо хронические кровопотери (длительные менструации, кровотечения из желудочно-кишечного тракта при язвенной болезни желудка).
Злокачественные болезни крови
Причиной примерно 15% всех тромбоцитозов являются гемобластозы – хронический миелоидный лейкоз, Ph-негативные миелопролиферативные патологии (эссенциальная тромбоцитемия, истинная полицитемия, а также первичный миелофиброз). Увеличение числа кровяных пластинок при этих болезнях обусловлено клональной (опухолевой) трансформацией мегакариоцитарного ростка костного мозга вследствие различных мутаций, что приводит к гиперпродукции тромбоцитов.
Данные болезни чаще встречаются у взрослых и людей пожилого возраста, у детей – лишь в исключительных случаях. Вначале тромбоцитоз умеренный, по мере прогрессирования он нарастает, достигая тяжелой или экстремальной степени, из-за чего часто возникают нарушения микроциркуляции, артериальные, венозные тромбозы различной локализации. Концентрация кровяных пластинок нормализуется очень медленно, только после курсов специфического миелосупрессивного лечения.
Спленэктомия
Селезенка, являясь органом, депонирующим кровь, удерживает большое количество форменных элементов, включая тромбоциты. Также селезенка принимает непосредственное участие в тромбоцитопоэзе, секретируя гормоны тромбоцитопенин, спленин, подавляющие костномозговое созревание мегакариоцитов. Поэтому тромбоцитоз после спленэктомии обусловлен двумя механизмами: выходом в циркулирующую кровь тромбоцитов, в норме находящихся в селезеночном депо, и феноменом «растормаживания костного мозга», т.е. усилением продукции тромбоцитов.
Увеличение количества кровяных пластинок возникает не сразу, а примерно через неделю после спленэктомии, достигает максимума к 13-14 дню (до 700-800 тыс.), нередко становясь причиной венозного тромбоза воротной вены, а затем медленно возвращается к норме за несколько недель или месяцев.
Травмы и операции
Массивное повреждение тканей (рана при полостной операции, перелом, обширные ожоги) вызывает активацию свертывающей системы крови, а именно сосудисто-тромбоцитарного звена, являющегося первым этапом гемостаза. Он подразумевает спазм сосудов, а также адгезию и агрегацию тромбоцитов в месте повреждения сосудистой стенки. Расход тромбоцитов стимулирует их активный выход из депо и компенсаторное усиление их костномозговой продукции. Объем повреждения коррелирует со степенью тромбоцитоза. Данный вид тромбоцитоза обычно не требует лечения.
Онкологические заболевания
Причиной тромбоцитоза при солидных (негемопоэтических) опухолях является способность раковых клеток продуцировать интерлейкин-6, стимулирующий тромбоцитопоэз. Такая особенность обнаружена при мелкоклеточном раке легких, аденокарциноме ободочной кишки, злокачественной мезотелиоме. Кроме того, распад опухоли часто вызывает кровотечения, приводя к железодефицитной анемии. Степень тромбоцитоза обычно умеренная, у детей может быть тяжелой, регрессирует после долгого лечения химиотерапевтическими средствами.
Редкие причины
- Функциональная аспления: серповидно-клеточная анемия, хронический алкоголизм, целиакия глютеновая.
- Использование лекарственных препаратов: винкристина, адреналина.
- Феномен рикошета: развитие тромбоцитоза через 1-2 недели после лечения тромбоцитопении или отмены медикаментов, вызывающих тромбоцитопению (метотрексата, витамина В12, преднизолона).
Диагностика
Тромбоцитоз выявляется в клиническом анализе крови. Хотя очень высокие показатели тромбоцитов чаще наблюдаются при гематологических заболеваниях, лишь по одному только уровню кровяных пластинок невозможно определить причину тромбоцитоза. Поэтому при его обнаружении следует посетить терапевта. Врач внимательно расспрашивает о жалобах пациента, давности возникновения симптомов, проводит общий осмотр больного. Затем на основании полученных данных назначается дополнительное обследование, включающее:
- Анализы крови. В общем анализе крови определяется содержание других форменных элементов (эритроцитов, лейкоцитов), проводится подсчет лейкоцитарной формулы. Измеряется концентрация воспалительных маркеров (СОЭ, СРБ). Оцениваются показатели сывороточного железа, ОЖСС, ферритина. Проверяется наличие аутоантител (РФ, АЦЦП, антител к цитоплазме нейтрофилов). При эндокардите, сепсисе выполняется анализ на прокальцитонин, пресепсин.
- Идентификация патогена. Для выявления возбудителя проводится микроскопия, бактериальный посев мочи, мокроты. При подозрении на туберкулез назначается внутрикожная проба с туберкулином. С помощью иммуноферментного анализа обнаруживаются антитела к вирусам, паразитам, грибкам, а методом полимеразной цепной реакции - их ДНК, РНК. Для диагностики менингита информативен анализ ликвора.
- Генетические исследования. У больных миелопролиферативными патологиями методом флуоресцентной гибридизации (FISH) и ПЦР определяются мутации янус-киназы (JAK2V617F), рецепторов тромбопоэтина (MPL), эритропоэтина. Иногда выявляются хромосомные аномалии – трисомии, делеции. При хроническом миелолейкозе цитогенетическим анализом обнаруживается филадельфийская хромосома (Ph).
- Рентген. На рентгенографии легких при пневмонии отмечаются очаги затемнения, инфильтраты, при туберкулезе – увеличение медиастинальных лимфоузлов, расширение корней легких, округлые тени (каверны) верхних долей легких. У пациентов с артритами на рентгенограмме суставов видны сужение суставной щели, участки эрозий, краевого остеопороза.
- УЗИ. На УЗИ органов брюшной полости при пиелонефрите определяется уплотнение, расширение чашечно-лоханочной системы, при заболеваниях крови – спленомегалия. При бактериальном эндокардите на эхокардиографии сердца находят вегетации клапанов, иногда выпот в перикардиальную полость.
- Эндоскопия. У больных с воспалительными патологиями кишечника выполняется фиброколоноскопия, при которой обнаруживаются гиперемия слизистой, отсутствие сосудистого рисунка, эрозии, язвенные дефекты. Для болезни Крона характерен симптом «булыжной мостовой» - чередование глубоких язв с неизмененной слизистой оболочкой.
- Гистологические исследования. В пунктате костного мозга при злокачественных гематологических патологиях отмечается гиперплазия мегакариоцитарного ростка кроветворения (при истинной полицитемии – всех трех ростков), большое количество бластных клеток (при миелолейкозе), разрастание ретикулиновых и коллагеновых волокон (фиброз). При васкулитах в биоптате сосуда выявляется выраженная периваскулярная инфильтрация лимфоцитами, плазмоцитами.

Коррекция
Консервативная терапия
В большинстве случаев, чтобы скорректировать тромбоцитоз, достаточно искоренения причины, т.е. лечения основного заболевания. Кратковременный тромбоцитоз, развившийся на фоне стресса или введения лекарственных препаратов, не требует вмешательства. При стойком длительном тромбоцитозе необходима консультация гематолога для выявления причины, назначения соответствующего лечения. Терапия тромбоцитозов имеет несколько направлений, включающих:
- Борьба с инфекцией. Для элиминации инфекционного агента используются антибактериальные (амоксициллин), противогрибковые (флуконазол), противопаразитарные средства (мебендазол). Лечение вирусных гепатитов требует длительного применения пелигированного интерферона в комбинации с противовирусными лекарствами.
- Лечение железодефицитной анемии. Коррекция железодефицита проводится таблетированными препаратами (железа сульфата). Для детей существуют формы сиропа, капель для приема внутрь. Лучшему усвоению способствует добавление аскорбиновой кислоты.
- Терапия аутоиммунных болезней. Лечение аутоиммунных заболеваний осуществляется применением медикаментов, подавляющих воспаление – глюкокортикостероидов (преднизолон), иммуносупрессантов (циклофосфамид).
- Таргетная терапия. При миелопролиферативных заболеваниях назначается специфическое таргетное (прицельное) лечение, позволяющее замедлить прогрессирующий рост злокачественной опухоли. К таким препаратам относят ингибиторы янус-киназы (руксолитиниб), тирозин-киназы (иматиниб, дазатиниб).
- Симптоматическое лечение. Для купирования высокого тромбоцитоза используются медикаменты, подавляющие активность мегакариоцитарного ростка, а, следовательно, и выработку тромбоцитов – анагрелид, интерферон-альфа, гидроксимочевина. При полицитемии для удаления избытка форменных элементов как метод лечения успешно применяются регулярные кровопускания.
- Разжижжение крови. При высоком тромбоцитозе с целью предупреждения тромбообразования назначаются антиагреганты (ацетилсалициловая кислота). При противопоказаниях (язвенная болезнь желудка, 12-перстной кишки) применяются блокаторы тромбоцитарных рецепторов (клопидогрель, тикагрелор). У лиц, имеющих высокий риск тромбозов (пожилые, больные сахарным диабетом или фибрилляцией предсердий), используются антикоагулянты (варфарин, дабигатран).
Специализированное лечение
Единственный метод, позволяющий добиться полного исцеления от злокачественного гематологического заболевания – это аллогенная трансплантация костного мозга. Для этого необходимо проведение HLA-типирования для подбора совместимого донора. Однако по причине высокого риска развития жизнеугрожающих осложнений к данному способу прибегают только при неэффективности консервативного лечения.
Прогноз
Исход зависит как от основной патологии, так и от степени тромбоцитоза. Например, острая вирусная инфекция, железодефицитная анемия характеризуются доброкачественным течением. Больные эссенциальной тромбоцитемией при грамотном подборе патогенетического и симптоматического лечения могут прожить больше 80 лет. Люди с хроническим миелолейкозом, напротив, живут около 5-10 лет с момента постановки диагноза.
Так как у детей почти всегда встречается реактивный тромбоцитоз, у них прогноз благоприятный. Для мягкого и умеренного тромбоцитоза нетипично тромбообразование. При экстремальной или тяжелой степени существует очень большая вероятность фатальных тромбозов, приводящих к инфаркту миокарда, легкого, ишемическому инсульту.
1. Патофизиология системы крови. Часть II. Нарушения в системе лейкоцитов/ Николаева О.В., Кучерявченко М.А., Шутова Н.А. и др. – 2016.
Тромбоцитопения
Тромбоцитопения – количественное нарушение тромбоцитарного звена гемостаза, характеризующееся снижением количества тромбоцитов в единице объема крови. Клинические признаки тромбоцитопении включают повышенную кровоточивость из поврежденной кожи и слизистых, склонность к образованию синяков и геморрагической сыпи, спонтанные кровотечения различных локализаций (носовые, десневые, желудочные, маточные и др.). Гематологическая диагностика основывается на изучении общего анализа крови с подсчетом тромбоцитов, иммунологическом обследовании, исследовании пунктата костного мозга. Возможными методами лечения тромбоцитопении являются медикаментозная терапия, спленэктомия, экстракорпоральное очищение крови.


Тромбоцитопении – различные по этиологии, патогенезу и течению геморрагические диатезы, характеризующиеся склонностью к повышенной кровоточивости вследствие уменьшения количества кровяных пластинок. Пороговым критерием тромбоцитопении в гематологии принято считать уровень тромбоцитов ниже 150х109/л. Однако развернутая клиническая картина тромбоцитопении обычно развивается при снижении тромбоцитов до 50х109/л, а уровень 30х109/л и ниже является критическим. Физиологическая тромбоцитопения, возникающая у женщин в период менструации или беременности (гестационная тромбоцитопения), обычно не достигает выраженной степени. Патологические тромбоцитопении, обусловленные различными причинами, встречаются у 50-100 человек из 1 млн.
Тромбоциты (бляшки Биццоцеро) представляют собой мелкие кровяные пластинки размером 1-4 мкм. Они образуются из мегакариоцитов костного мозга при непосредственном стимулирующем воздействии полипептидного гормона тромбопоэтина. Нормальный уровень тромбоцитов составляет 150-400х109/л; примерно 70% тромбоцитов непрерывно циркулирует в периферической крови, а 1/3 часть находится в селезеночном депо. Средняя продолжительность жизни тромбоцитов составляет 7-10 дней, после чего происходит их разрушение в селезенке.
Причины тромбоцитопении
Врожденные тромбоцитопении в большинстве своем являются частью наследственных синдромов, таких как синдром Вискота-Олдрича, анемия Фанкони, синдром Бернара-Сулье, аномалия Мея-Хегглина и др. Поскольку при наследственных тромбоцитопениях, как правило, наблюдаются также качественные изменения тромбоцитов, их принято относить к тромбоцитопатиям.
Причины приобретенных тромбоцитопений крайне разнообразны. Так, возмещение кровопотери инфузионными средами, плазмой, эритроцитарной массой может привести к уменьшению концентрации тромбоцитов на 20-25% и возникновению, так называемой, тромбоцитопении разведения. В основе тромбоцитопении распределения лежит секвестрация тромбоцитов в селезенке или сосудистых опухолях – гемангиомах с выключением значительного количества тромбоцитарной массы из общего кровотока. Тромбоцитопении распределения могут развиваться при заболеваниях, сопровождающихся массивной спленомегалией: лимфомах, саркоидозе, портальной гипертензии, туберкулезе селезенки, алкоголизме, болезни Гоше, синдроме Фелти и др.
Наиболее многочисленную группу составляют тромбоцитопении, обусловленные повышенным разрушением тромбоцитов. Они могут развиваться как в связи с механическим разрушением тромбоцитов (например, при протезировании сердечных клапанов, искусственном кровообращении, пароксизмальной ночной гемоглобинурии), так и при наличии иммунного компонента.
Аллоиммунные тромбоцитопении могут являться следствием трансфузии иногруппной крови; трансиммунные – проникновения материнских антител к тромбоцитам через плаценту к плоду. Аутоиммунные тромбоцитопении связаны с выработкой антител к собственным неизмененным антигенам тромбоцитов, что встречается при идиопатической тромбоцитопенической пурпуре, системной красной волчанке, аутоиммунном тиреоидите, миеломной болезни, хроническом гепатите, ВИЧ-инфекции и др.
Гетероиммунные тромбоцитопении обусловлены образованием антител против чужеродных антигенов, фиксирующихся на поверхности тромбоцитов (лекарственных, вирусных и др.). Лекарственно-индуцированная патология возникает при приеме седативных, антибактериальных, сульфаниламидных препаратов, алкалоидов, соединений золота, висмута, инъекциях гепарина и др. Обратимое умеренное снижении числа тромбоцитов наблюдается после перенесенных вирусных инфекций (аденовирусной инфекции, гриппа, ветряной оспы, краснухи, кори, инфекционного мононуклеоза), вакцинации.
Тромбоцитопении, обусловленные недостаточным образованием тромбоцитов (продуктивные), развиваются при дефиците стволовых гемопоэтических клеток. Такое состояние характерно для апластической анемии, острого лейкоза, миелофиброза и миелосклероза, опухолевых метастазов в костный мозг, дефицита железа, фолиевой кислоты и витамина B12, эффектов лучевой терапии и цитостатической химиотерапии.
Наконец, тромбоцитопения потребления возникает в связи с повышенной потребностью в тромбоцитах для обеспечения свертываемости крови, например, при ДВС-синдроме, тромбозах и т. д.

Тромбоцитопении принято классифицировать на основании ряда признаков: причин, характера синдрома, патогенетического фактора, тяжести геморрагических проявлений. По этиологическому критерию различают первичные (идиопатические) и вторичные (приобретенные) тромбоцитопении. В первом случае синдром является самостоятельным заболеванием; во втором – развивается вторично, при ряде других патологических процессов.
Тромбоцитопения может иметь острое течение (длительностью до 6 месяцев, с внезапным началом и быстрым снижением количества тромбоцитов) и хроническое (длительностью более 6 месяцев, с постепенным нарастанием проявлений и снижением уровня тромбоцитов).
С учетом ведущего патогенетического фактора выделяют:
- тромбоцитопении разведения
- тромбоцитопении распределения
- тромбоцитопении потребления
- тромбоцитопении, обусловленные недостаточным образованием тромбоцитов
- тромбоцитопении, обусловленные повышенным разрушением тромбоцитов: неиммунные и иммунные (аллоиммунные, аутоиммунные, трансиммунные, гетероиммунные)
Критерием тяжести тромбоцитопении служит уровень тромбоцитов крови и степень нарушения гемостаза:
- I - количество тромбоцитов 150-50х109/л – гемостаз удовлетворительный
- II - количество тромбоцитов 50-20 х109/л – при незначительной травме возникают внутрикожные кровоизлияния, петехии, длительные кровотечения из ран
- III - количество тромбоцитов 20х109/л и ниже – развиваются спонтанные внутренние кровотечения.
Симптомы тромбоцитопении
Обычно первым сигналом снижения уровня тромбоцитов служит появление кожных кровоизлияний при незначительном травмировании (ударе, сдавлении) мягких тканей. Больные отмечают частое возникновение синяков, специфической мелкоточечной сыпи (петехий) на теле и конечностях, кровоизлияний в слизистые оболочки, повышенную кровоточивость десен и т. п. В этот период тромбоцитопения выявляется лишь на основании изменений гемограммы, чаще исследуемой по другому поводу.
На следующем этапе отмечается увеличение времени кровотечения при незначительных порезах, длительные и обильные менструальные кровотечения у женщин (меноррагии), появление экхимозов в местах инъекций. Кровотечение, вызванное травмой или медицинской манипуляцией (например, экстракцией зуба) может продолжаться от нескольких часов до нескольких суток. Спленомегалия при тромбоцитопении обычно развивается только на фоне сопутствующей патологии (аутоиммунной гемолитической анемии, хронического гепатита, лимфолейкоза и пр.); увеличение печени не характерно. В случае присоединения артралгии следует думать о наличии у пациента коллагеноза и вторичном характере тромбоцитопении; при склонности к образованию глубоких висцеральных гематом или гемартрозов – о гемофилии.
При значительном снижении количества тромбоцитов возникают спонтанные кровотечения (носовые, маточные, легочные, почечные, желудочно-кишечные), выраженный геморрагический синдром после хирургических вмешательств. Профузные некупируемые кровотечения и кровоизлияния в мозг могут стать фатальными.

При любых состояниях, сопровождающихся повышенной кровоточивостью, следует обратиться к гематологу. Первым тестом на пути диагностики тромбоцитопении служит исследование общего анализа крови с подсчетом количества тромбоцитов. Мазок периферической крови может указывать на возможную причину тромбоцитопении: присутствие ядросодержащих эритроцитов или незрелых лейкоцитов скорее всего свидетельствует в пользу гемобластоза и требует более углубленного обследования (проведения стернальной пункции, трепанобиопсии).
Для исключения коагулопатии исследуется гемостазиограмма; при подозрении на аутоиммунный характер тромбоцитопении производится определение антитромбоцитарных антител. Возможную причину тромбоцитопении позволяет выявить УЗИ селезенки, рентгенография грудной клетки, иммуноферментный анализ крови. Дифференциальная диагностика проводится между различными формами тромбоцитопений, а также с болезнью Виллебранда, гемофилией, пернициозной анемией, тромбоцитопатиями и др.
Лечение тромбоцитопении
При установлении вторичного характера тромбоцитопении основное лечение заключается в терапии основного заболевания. Вместе с тем, наличие выраженного геморрагического синдрома требует госпитализации пациента и оказания неотложной медицинской помощи. При активных кровотечениях показаны трансфузии тромбоцитов, назначение ангиопротекторов ( этамзилаа), ингибиторов фибринолиза (аминокапроновой кислоты). Исключается прием ацетилсалициловой кислоты, антикоагулянтов, НПВС.
Пациентам с идиопатической тромбоцитопенической пурпурой проводится глюкокортикоидная терапия, внутривенное введение иммуноглобулина, плазмаферез, химиотерапия цитостатиками. В отдельных случаях (при неэффективности медикаментозной терапии, повторных кровотечениях) показана спленэктомия. При тромбоцитопениях неиммунного характера проводится симптоматическая гемостатическая терапия.
Врожденные внутренние нарушения тромбоцитов
Врожденные и приобретенные формы тромбоцитопении - признаки
При дифференциальной диагностике идиопатической тромбоцитопенической пурпуры следует иметь в виду и другие тромбоцитопении, периферического или центрального происхождения, обычно более редкие.
Среди тромбоцитопении центрального происхождения хорошо известны обыкновенные тромбоцитопении как приобретенные формы при медуллярных аплазиях с общими или частичными гемоцитопениями.
Реже встречаются известные врожденные формы с различным патогенезом, по поводу периферических тромбоцитарных или центральных медуллярных альтераций, в том числе:
1) Амегакариоцитарная тромбоцитопения, врожденная, ассоциированная с множественными почечными, костными, эритроцитарными изменениями. Возникает при рождении, возможно по поводу вирусных внутриматочных инфекций или после толбутамида, причем прогноз является очень тяжелым (Eisenstein, Dignan и сотр.). Несколько менее тяжелая форма, без других аномалий — форма по поводу врожденного порока тромбоцитарного фактора, с отсутствием определенных гранулярных компонентов (Shulmann и сотр.).
2) Среди наследственных тромбоцитопении, встречаемых в некоторых семьях, описываются так называемые формы sex-linked (связанные с полом), в рамках синдрома Wiscott-Aldrich, с внутритромбоцитарными дефектами; среди них известна аномалия Мей-Гегглина (May-Hegglin) с гигннтскими тромбоцитами и включениями в гранулоцитах (тела Dohle); при них имеется врожденный порок тромбоцитов с коротким жизненным сроком и дефицитом аггрегации и выведения F3 (Kurtjens и сотр., Grottam и Salmon), а также и поверхностные электрические аномалии с сокращением грануляций альфа (Niewiartowski и сотр.).
3) Редкие случаи понижения мегакариоцитов с тяжелой пурпурой цитировались у детей рожденных от матерей, леченных диуретическими тиазидами, которые однако, за несколькими исключениями, вылечиваются за несколько недель (Rodriguez и сотр.).

Среди факторов редких приобретенных тромбоцитопений, которые не следует смешивать с идиопатической тромбоцитопенической пурпурой отмечаются:
1) умеренные тромбоцитопении после длительного применения диуретических тиазидов, оказывающих медуллодепрессивное действие на мегакариоциты (Gesing и Bedford, Kurt и Weinfeld);
2) умеренные и очень редко тяжелые тромбоцитопении у хронических алкоголиков и реже при остром алкоголизме. Они происходят благодаря ингибирующему действию алкоголя на мегакариоциты, причем тромбоциты приходят в норму за 7—21 день после выведения алкоголя (Rindelbaum, Post и Desfarges, Sullivan);
3) при состояниях гиперэстрогении у женщин или мужчин после лечения эстрогенами, также с центральной ингибицией, появляются, еще не полностью доказанные, тромбоцитопении как те, которые бывают во время менструального предцикла (Cooper и Bigelow, Pohle).
Однако у некоторых женщин, предменструальное понижение тромбоцитов бывает очень сильным, детерминируя пурпуровые явления, но у большинства женщин эти понижения составляют около 20%, без появления пурпуры (Bernard и Caen, Wilkinson и Firkin). Вполне вероятно, что существует регулирование тромбоцитопозза путем периферического фидбека (feed-back) по режиму секреции эстрогенов (Morley и сотр.). У некоторых женщин происходят циклические тромбоцитопении по поводу центральной ингибиции, возможно из-за расстройства нормального фидбека.
Другие дефекты в центральном производстве тромбоцитов встречаются при сложных метаболических дефицитах благодаря недостатку известных гематопоэтических факторов, как например при мегалобластических анемиях, а также и при гипохромных анемиях по поводу глобального дефицита Fe, ассоциированного с дефицитом фолиевой кислоты, как при некоторых расстройствах на почве кишечной мальабсорбции. Вирусные инфекции, наряду с иммунным механизмом, детерминирующим идиопатическую тромбоцитопеническую пурпуру, могут порождать периферические и центральные тромбоцитопении благодаря непосредственному действию в периоды гипервиремии.
Читайте также:
- Буллезный пемфигоид Левера. Диагностика и лечение буллезного пемфигоида.
- Состояние терапевтической офтальмологии. Отечественная офтальмология
- Диагностика гемолитической болезни новорожденных. Лечение гемолитической болезни новорожденных
- Рак фатерова сосочка. Анатомия и физиология поджелудочной железы
- Клиническая диагностика первично-множественных опухолей. Первично-множественный рак и метастазы
